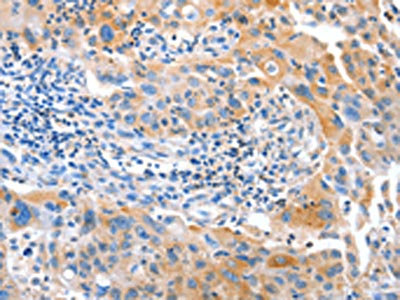

-
中文名稱:IMMT兔多克隆抗體
-
貨號:CSB-PA598310
-
規格:¥1100
-
圖片:
-
The image on the left is immunohistochemistry of paraffin-embedded Human colon cancer tissue using CSB-PA598310(IMMT Antibody) at dilution 1/12, on the right is treated with fusion protein. (Original magnification: ×200)
-
The image on the left is immunohistochemistry of paraffin-embedded Human breast cancer tissue using CSB-PA598310(IMMT Antibody) at dilution 1/12, on the right is treated with fusion protein. (Original magnification: ×200)
-
Gel: 8%SDS-PAGE, Lysate: 40 μg, Lane 1-2: Hela cells, 231 cells, Primary antibody: CSB-PA598310(IMMT Antibody) at dilution 1/250, Secondary antibody: Goat anti rabbit IgG at 1/8000 dilution, Exposure time: 1 minute
-
-
其他:
產品詳情
-
Uniprot No.:
-
基因名:IMMT
-
別名:IMMT; HMP; MIC60; MINOS2; PIG4; PIG52; MICOS complex subunit MIC60; Cell proliferation-inducing gene 4/52 protein; Mitochondrial inner membrane protein; Mitofilin; p87/89
-
宿主:Rabbit
-
反應種屬:Human,Mouse
-
免疫原:Fusion protein of Human IMMT
-
免疫原種屬:Homo sapiens (Human)
-
標記方式:Non-conjugated
-
抗體亞型:IgG
-
純化方式:Antigen affinity purification
-
濃度:It differs from different batches. Please contact us to confirm it.
-
保存緩沖液:-20°C, pH7.4 PBS, 0.05% NaN3, 40% Glycerol
-
產品提供形式:Liquid
-
應用范圍:ELISA,WB,IHC
-
推薦稀釋比:
Application Recommended Dilution ELISA 1:2000-1:5000 WB 1:500-1:2000 IHC 1:15-1:50 -
Protocols:
-
儲存條件:Upon receipt, store at -20°C or -80°C. Avoid repeated freeze.
-
貨期:Basically, we can dispatch the products out in 1-3 working days after receiving your orders. Delivery time maybe differs from different purchasing way or location, please kindly consult your local distributors for specific delivery time.
-
用途:For Research Use Only. Not for use in diagnostic or therapeutic procedures.
相關產品
靶點詳情
-
功能:Component of the MICOS complex, a large protein complex of the mitochondrial inner membrane that plays crucial roles in the maintenance of crista junctions, inner membrane architecture, and formation of contact sites to the outer membrane. Plays an important role in the maintenance of the MICOS complex stability and the mitochondrial cristae morphology.
-
基因功能參考文獻:
- Sub-mitochondrial localization of the genetic-tagged mitochondrial intermembrane space-bridging components Mic19, Mic60 and Sam50. PMID: 28808085
- PKA-mediated phosphorylation of MIC60 negatively regulates mitochondrial clearance that is initiated by PINK1 and Parkin. PMID: 27153535
- Mitofilin-knockdown cells showed decreased mitochondrial membrane potential (DeltaPsim) and intracellular ATP content, which were minimally affected in CHCHD6-knockout cells. PMID: 26530328
- Mic60 interacted with mtDNA and was involved in the architecture of mtDNA D-loop region. Taken together, our findings reveal a previously unrecognized important role of Mic60 in mtDNA transcription. PMID: 25612828
- Mitofilin, a mitochondria protein, is shown to be related to cardiac hypertrophy for the first time, which enhances our understanding of the role of mitochondria in cardiac hypertrophy. PMID: 24555791
- Transgenic overexpression of mitofilin preserves mitochondrial structure, leading to restoration of mitochondrial function and attenuation of cardiac contractile dysfunction in the diabetic heart. PMID: 25463274
- APOOL is a cardiolipin-binding component of the Mitofilin/MINOS protein complex. PMID: 23704930
- mitofilin distinctly functions in mitochondrial cristae remodeling and controls cytochrome c release during apoptosis. PMID: 23058921
- CHCM1/CHCHD6, novel mitochondrial protein linked to regulation of mitofilin and mitochondrial cristae morphology. PMID: 22228767
- The mitochondrial dysfunction induced by DISC1 deficiency was partially reversed by coexpression of Mitofilin, confirming a functional link between DISC1 and Mitofilin for the normal mitochondrial function. PMID: 20880836
- Data show that the nuclear matrix protein matrin 3, cytoskeletal motor protein HMP, and the circadian clock protein lark were significantly decreased in fetal Down syndrome brain. PMID: 12469345
- mitofilin is a critical organizer of the mitochondrial cristae morphology and thus indispensable for normal mitochondrial function PMID: 15647377
- role in protein import related to maintenance of mitochondrial structure is suggested; mitofilin helps regulate mitochondrial morphology and four of the associated proteins (metaxins 1 and 2, SAM50 and CHCHD3) have been implicated in protein import PMID: 17624330
顯示更多
收起更多
-
亞細胞定位:Mitochondrion inner membrane; Single-pass membrane protein. Mitochondrion.
-
蛋白家族:MICOS complex subunit Mic60 family
-
數據庫鏈接:
Most popular with customers
-
-
YWHAB Recombinant Monoclonal Antibody
Applications: ELISA, WB, IHC, IF, FC
Species Reactivity: Human, Mouse, Rat
-
Phospho-YAP1 (S127) Recombinant Monoclonal Antibody
Applications: ELISA, WB, IHC
Species Reactivity: Human
-
-
-
-
-